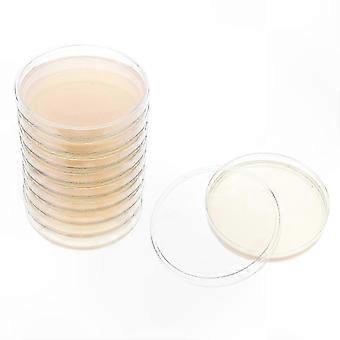

VÝPREDAJ Petriho misky
Za nízke ceny si teraz môžete zakúpiť až 3 755 výrobkov z kategórie petriho misky v ZĽAVOVEJ AKCII. UŠETRITE na zľavách a výpredajoch značiek petriho misky v ZĽAVOVEJ AKCII Fruugo s výraznou úsporou a lacnou ponukou v kategórii McKesson, Exsha, Lee's a iné. Kúpte si petriho misky online a bezpečne v ZĽAVOVEJ AKCII Fruugo s možnosťou bezpečnej platby a rýchleho doručenia na Slovensko.
Filtre
129 - 160 z 3 755